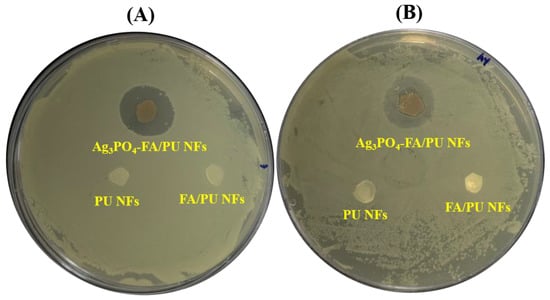

Abstract
Visible-light-responsive silver-phosphate-sensitized fly-ash particles loaded on polyurethane nanofiber (Ag3PO4–FA/PU NFs) membrane photocatalysts were prepared by electrospinning followed by an ion-exchange method and characterized with state-of-art techniques. With the assistance of Ag3PO4–FA/PU NFs, 98 % of methylene blue (MB) was degraded within 60 min. The combination of FA and Ag3PO4 particles provided simultaneous adsorption and degradation of MB in an aqueous solution, resulting in the fast removal of the dye. Also, the Ag3PO4–FA/PU NFs exhibited excellent antibacterial performance toward Escherichia coli and Staphylococcus aureus bacteria. Thus, the prepared photocatalyst may provide a potential outcome for environmental remediation, especially wastewater treatment applications.
1. Introduction
Fly ash (FA) is a primary solid residue produced during the combustion of coal [1,2]. If not properly disposed of, it can result in serious consequences for the environment and human health [3,4]. FA is primarily composed of silica and alumina. Besides aluminosilicate, it also contains magnesium oxides, iron oxide, titanium oxide, and calcium oxide [3,5]. For a long time, the utilization of FA was limited to building materials [6]. Over the past decades, researchers have devoted significant efforts to exploring FA in various applications such as photocatalysis [3,7,8], adsorption [9,10], fire retardance [11], etc. by fabricating nanocomposites. In particular, FA has been proven to be a highly efficient adsorbent for the removal of heavy metals and dyes from water [12,13]. Although previous studies have shown that FA could be used as an adsorbent, its adsorption capacity is still low. Furthermore, the separation, recovery, and reuse of FA particles may hinder their practical applications. Composite of semiconductor metal oxides with FA particles has not only shown combined photocatalytic and adsorption properties but also lowered the chance of secondary pollution [3,14].
Silver-based visible-light-active photocatalysts such as Ag2CO3 [15,16], Ag3PO4 [17,18], AgI [19], AgBr [20], and Ag3VO4 [21] have been extensively studied for controlling environmental pollution. Among them, Ag3PO4 has attracted considerable attention as a promising photocatalytic and antibacterial material due to its narrow band gap and visible light response [22,23]. For example, Luo et al. [24] prepared Ag3PO4 photocatalysts via the precipitation method and investigated their efficiency for photodegradation of volatile organic compounds and cationic and anionic dyes. Krungchanuchat et al. [25] prepared UV-visible light-active Ag3PO4 dodecahedral particles via the hydrothermal method and reported an RhB degradation efficiency of 99.55% in UV light within 120 min. Thiyagarajan et al. synthesized solar light-active Ag3PO4 particles with good antibacterial properties [22]. Despite their easy preparation and good performance, rapid recombination of the photogenerated electron–hole pairs and photocorossion of Ag3PO4 particles are major drawbacks in photocatalysis [17]. Many researchers have adopted a composite approach to address these issues. For example, the coupling of Ag3PO4 with TiO2 [17], MoS2 [26], CuO [27], WO3 [28], g-C3N4 [29], and ZnO [30] have been reported with increased photocatalytic activities. As adsorption is a prerequisite for good photocatalysts, coupling Ag3PO4 with an adsorbent material could provide simultaneous adsorption and photodegradation of the dye molecules. Hence, sensitizing FA with Ag3PO4 nanoparticles (NPs) could be an appropriate strategy to obtain a combined effect of photocatalyst and adsorbent material. However, the agglomeration tendency of nanostructure photocatalysts decreases their efficiency. Therefore, it is crucial to discover an efficient approach to overcome these obstacles.
In recent years, electrospinning has emerged as a famous technique to prepare organic/or inorganic nanofibers and their composites for various applications such as filtration, photocatalysis, energy storage and convergence, and biomedical [31,32]. In particular, electrospun fibers have gained widespread attention in photocatalysis due to several outstanding features such as a controllable morphology, high surface-area-to-volume ratio, mechanical properties, easy synthetic protocol, porous structures, etc. [3,17]. Additionally, various photocatalytic nanoparticles can be easily assembled into electrospun nanofibers, which can enhance the photocatalytic property of the resulting materials [33]. So far, a number of effective photocatalytic nanoparticles such as metal/metal oxides, metal halides, and metal sulfides have been loaded into electrospun fibers for effective removal of organic pollutants from water [33,34,35,36]. Yu et al. [37] synthesized necklace-like Ag3PO4–polyacrylonitrile nanofibers via the electrospinning method and studied the degradation of organic contaminants under visible light irradiation. Habib et al. [38] immobilized a Ag3PO4/P25 composite into poly(methyl methacrylate)/polyvinylchloride nanofibers for the photocatalytic degradation of methyl orange and the destruction of E. coli.
Based on the above-provided explanations, in this study, we prepared Ag3PO4 nanoparticles decorated by FA-assembled polyurethane nanofiber (Ag3PO4–FA/PU NFs) membranes via electrospinning and ion-exchange methods. Generally, the process of incorporating photocatalytic NPs into electrospun nanofibers involves adding the NPs to the polymer solution before electrospinning. However, it may cause aggregation of NPs, thereby limiting the efficiency of the composite. Although the hydrothermal method has been employed to load or develop various NPs into the nanofibers, it may result in poor attachments, which not only hampers the reusability of the composite but also may cause secondary pollution. Therefore, as a facile and feasible approach, we employed a two-step strategy to develop Ag3PO4–FA/PU composite nanofibers. In the first step, the FA particles and AgNO3 were immobilized into the PU NFs via the electrospinning method. Second, an ion-exchange reaction between AgNO3 and disodium phosphate was carried out to obtain Ag3PO4 NPs on the surface of nanofibers. The synergistic effects of Ag3PO4 between FA particles in PU nanofibers were tested for photocatalytic removal of methylene blue and bactericidal effects against Escherichia coli (E. coli) and Staphylococcus aureus (S. aureus) bacteria. Based on the results obtained, the synthesized material can be considered an effective medium for wastewater treatment.
2. Experimental
2.1. Materials
Polyurethane pellets (Skythane X595A-11) were obtained from Lubrizol Advanced Materials, Inc., Wickliffe, OH, USA. Tetrahydrofuran (THF) and N,N-Dimethylformamide (DMF) were obtained from Showa Chemicals Ltd., Tokyo, Japan. Disodium hydrogen phosphate dehydrate (Na2HPO4.2H2O) and silver nitrate (AgNO3) were purchased from Sigma-Aldrich, St. Louis, MO, USA. Purified fly ash was obtained from Won Engineering Company Ltd. (Gunsan, South Korea). All chemicals were used as received.
2.2. Preparation of AgNO3/FA/PU Nanofibers Membrane
A 10% PU solution was prepared by dissolving PU in a mixed solvent system of THF/DMF (1:1 weight) for 12 h via stirring at room temperature. Fly ash particles (20 Wt % with respect to PU) were added into the solution and magnetically stirred for 6 h. Next, 250 mg of AgNO3 powder was added to the solution and stirred for 3 h to get a viscous solution. The solution was then moved into a plastic syringe and electrospun at 18 kV. During electrospinning, the tip-to-collector distance and the solution feed rate were set at 0.5 mL/h and 15 cm, respectively. The nanofibers were collected in a polyethylene sheet and subjected to vacuum drying at 30 °C for 6 h to evaporate the residual solvent. For comparison, pristine PU nanofibers were also prepared by the aforementioned process without using AgNO3. For comparison, FA particle-decorated PU nanofiber membranes (FA/PU NFs) were also prepared by the same process without using AgNO3.
2.3. Preparation of Ag3PO4–FA/PU Nanofiber Membrane
For the preparation of the Ag3PO4–FA/PU nanofiber, the as-obtained electrospun membrane was immersed in 100 mL of water containing 200 mg of Na2HPO4 for 12 h at room temperature. The color of the membrane was shifted from white to yellowish, indicating the formation of Ag3PO4 particles on the PU fibers. The treated membrane was washed multiple times and then dried at 60 °C for 6 h.
2.4. Characterization
The phase structures of the prepared samples were analyzed by an X-ray diffractometer (Rigaku Co., Tokyo, Japan) with Cu Kα (λ = 1.54 Å). The nano-topographical aspects of the samples were explored by field emission scanning electron microscopy (FESEM, Carl Zeiss Supra-40 VP, Oberkochen, Germany) and energy-dispersive X-ray spectroscopy (EDS). High-resolution images were obtained via transmission electron microscopy (TEM, JEOL, Tokyo, Japan). The chemical structures were investigated by Fourier transform infrared (FTIR) spectra (ABB Bomen MB 100 Spectrometer, Quebec, QC, Canada).
2.5. Antibacterial Performance
The antibacterial performance of the various formulations (PU NFs, FA/PU NFs, and Ag3PO4–FA/PU NFs) was investigated against Gram-negative Escherichia coli (E. coli) and Gram-positive Staphylococcus aureus (S. aureus) bacteria following the zone inhibition method in accordance with our previous studies [39,40]. Initially, we cultured the bacteria in a tryptone soy broth at 37 °C for 12 h and prepared a bacterial preculture suspension of 108 CFU/mL. Next, the nanofiber membranes were cut into a circular disk shape with a diameter of about 6 mm and rinsed with a phosphate-buffered saline (PBS) solution before being sterilized using UV light. Afterward, 100 µL of the stock bacterial suspension was spread on a tryptone soy agar plate. Then, the samples were carefully positioned over the plate. Following incubation for 24 h at 37 °C, the agar plate was visually examined, and the results were documented. The size of the zone of the inhibition was measured by determining the diameter of the inhibition area around the disk.
2.6. Dye Degradation Studies
The catalytic performance of the as-prepared Ag3PO4–FA/PU NFs membrane was investigated by degrading MB under visible-light irradiation. First, the adsorption–desorption equilibrium was developed by treating 25 mg of the sample with 50 mL of MB solution (10 ppm) for 30 min in dark conditions. Secondly, the photocatalytic reaction proceeded under visible light (Xe lamp, 300 W) by constant stirring. During the irradiation, 1 mL of the sample was withdrawn at a specific time and the absorbance change of the solution was monitored by measuring absorption intensity via spectrophotometer. The reusability of the sample was tested for three successive cycles following the same method as mentioned above.
3. Results and Discussion
The formation of Ag3PO4 NPs and the presence of FA particles on the PU nanofibers were determined via XRD analysis (Figure 1). The pristine PU NFs exhibited a broad peak at the 2θ values of ~20°, representing a semi-crystalline structure [39]. On the other hand, the FA/PU composite sample showed additional peaks for mullite and quartz, which are similar to our previous reports [3,7]. We also measured the XRD spectra of the AgNO3–FA/PU composite sample and observed similar peaks as those of FA/PU NFs. This finding confirms that there was no reduction of AgNO3 occurred in the fibers. Compared to the FA/PU NFs, the Ag3PO4–FA/PU NFs showed several extra peaks which are well matched with the cubic structure of Ag3PO4 (JCPDS card No. 06-0505) [17,41]. Therefore, it confirms the successful formation of Ag3PO4 by the reaction between AgNO3 and NaHPO4.

Figure 1.
XRD spectra of various formulations of electrospun nanofiber membranes.
The morphologies of the pristine and composite nanofibers were studied by FESEM (Figure 2). In all cases, it showed continuous and distributed bead-free random nanofibers with a typical three-dimensional (3D) network commonly appearing in electrospun nanofibers. The average diameter of pristine PU nanofibers was 109 nm (Figure 2A’). After the addition of AgNO3 and FA particles, the overall fibrous morphology was not destroyed; however, it showed a rougher morphology with a slightly reduced fiber diameter (104 nm) (Figure 2B,B’). The reduction in fiber diameter is the result of the enhanced conductivity of the polymer solution by the addition of AgNO3 and FA particles. This finding is similar to our previous studies [11,39]. As in Figure 2B, a sheet-like FA flake attached to the surface of PU NF can be seen. Since the FA particles were mixed with the PU matrix prior to the electrospinning, the nano-sized particles were enclosed within the nanofibers, while the bigger particles were visible on the surface of the fibers. As FA is composed of various metal oxides, it may increase the electric charge in the polymer solution. The enhanced electric charge creates more stress on the whipping jet and forms subsidiary jets, thereby resulting in the formation of spider-web-like fibers along with the main fibers [39,42]. The Ag3PO4–FA/PU NFs exhibited a thickened morphology compared to other formulations. It should be noted that the AgNO3–FA/PU nanofibers were treated with a NaHPO4 aqueous solution for an ion-exchange reaction. This resulted in the swelling of the nanofibers. The average diameter was recorded to be 114 nm (Figure 2C’). The nanofibers were decorated with Ag3PO4 NPs with diameters ranging from 8 to 30 nm (Figure 2C). When the AgNO3–FA/PU nanofibers were kept in the NaHPO4 aqueous solution, the Ag+ ions combined with PO43- ions to form Ag3PO4 NPs on the surface of FA/PU fibers, thereby forming Ag3PO4–FA/PU composite nanofibers. The arrangement of Ag3PO4 NPs on the PU fibers can be seen in the TEM image (Inset of Figure 2C). The presence of Ag3PO4 and FA in the PU nanofibers was also verified via elemental mapping (Figure 3). The mapping results showed the existence of Ag, O, P, and C along with several constituents of FA (Si, Al, Ca, Mg, Fe, and Ti).

Figure 2.
FESEM images of Pristine PU NFs (A), AgNO3–FA/PU NFs (B), and Ag3PO4–FA/PU NFs (C) membranes. Inset C is the TEM image of Ag3PO4–FA/PU NFs. (A’), (B’), and (C’) are their respective diameter distribution curves.

Figure 3.
Elemental mapping of Ag3PO4–FA/PU NFs showing the various content on them.
The chemical structures of pristine PU NFs, FA/PU NFs, and Ag3PO4–FA/PU NFs were verified by their FTIR spectra (Figure 4). In pristine PU nanofibers, a broad peak around 3324 cm−1 is attributed to N-H bond stretching. The peaks at 2942 cm−1 and 2855 cm−1 represent CH3 symmetric and CH2 asymmetric vibrations, respectively. The stretching band of the carbonyl (C=O) is represented by a peak at 1705 cm−1. The peak at 1526 cm−1 is related to the NH bending. The peaks in the range of 1100–1260 cm−1 correspond to the asymmetric stretching of C-O-C [43,44]. In the case of FA/PU nanofibers, there was no change in the range of wavenumber from 1200 to 4000 cm−1. Below 1500 cm−1, two extra peaks were observed at 1176 and 460 cm−1, which corresponded to the silica and alumina framework of FA [11,45]. For Ag3PO4–FA/PU NFs, the characteristic peaks located at 971 cm−1 and 551 cm−1 were attributed to the asymmetric stretching of P-O and flexural vibration of P=O-P of PO4 groups, respectively [17,46].

Figure 4.
FTIR spectra of various samples.
Figure 5A shows the absorption spectra of MB dye solution obtained after treatment with Ag3PO4–FA/PU NFs at various times. A gradual decrease in the MB spectra was observed, presenting effective adsorption in dark and photocatalytic degradation under visible light irradiation. The photocatalytic performance of Ag3PO4–FA/PU NFs compared with other samples is given in Figure 5B. The control sample (PU NFs) showed no degradation. When FA was added into PU NFs, the resulting composite removed approximately 45% of the dye by a combined adsorption–degradation process. In this case, the removal of MB was mainly due to the adsorption properties of FA [3,47]. The adsorption test carried out under the dark condition showed about 25% of MB removal. As FA contains several metal oxides, it can also act as a photocatalyst; however, its catalytic ability is low [3]. Loading of Ag3PO4 NPs into the FA/PU NFs drastically enhanced photocatalytic efficiency. About 98% of MB was degraded after 1 h of visible light exposure. The enhanced photocatalytic performance by Ag3PO4–FA/PU NFs is attributed to the combined role of FA and Ag3PO4 for simultaneous adsorption and photocatalytic degradation [3,48].

Figure 5.
Time-dependent absorbance intensity of MB aqueous solution in the presence of Ag3PO4–FA/PU NFs (A), photocatalytic removal of MB by various samples before and after visible light irradiation (B), proposed photocatalytic mechanism (C), and cyclic stability tests (D).
A proposed mechanism of photocatalysis is given in Figure 5C. In the Ag3PO4–FA/PU NFs photocatalytic system, the FA particles mainly act as adsorbent material whereas the Ag3PO4 NPs serve as active photocatalysts. When the MB dye solution with the photocatalyst is exposed to solar light, first the dye molecules are adsorbed by the FA particles present in the photocatalyst. At the same time, photogenerated electrons and holes are formed in the conduction band (CB) and valance band (VB) of the Ag3PO4 NPs under light irradiation. The excited electrons in the CB of Ag3PO4 can migrate to FA particles and react with dissolved oxygen molecules to produce peroxide radicals (O2−•). At the same time, the hole can produce OH• radicals. The dye molecules were ultimately degraded by these two radicals [17]. Figure 5D verifies the cyclic stability of the photocatalyst for three successive cycles. Table 1 summarizes the performances of various Ag3PO4-based photocatalysts for pollutant degradation. Compared with similar materials in the literature, our material showed comparable or even better results for pollutant degradation.

Table 1.
Photocatalytic performance of the as-prepared Ag3PO4–FA/PU NFs photocatalyst compared with the other Ag3PO4 immobilized nanofiber-based materials.
We evaluated the antibacterial effects of as-synthesized PU NFs, FA/PU NFs, and Ag3PO4–FA/PU NFs against E. coli and S. aureus using the inhibition zone method, and the results of the toxicity assessment are given in Figure 6. Both pristine PU and FA/PU NFs membranes did not exhibit any bacteriostatic zone, indicating no antibacterial activities. However, the Ag3PO4–FA/PU NFs membrane showed significant inhibition zones towards E. coli and S. aureus, demonstrating excellent antibacterial properties against both Gram-positive and Gram-negative bacteria. The diameter of inhibition zones for E. coli and S. aureus were recorded as ~16 mm and ~15 mm, respectively. The slightly higher antibacterial action against E. coli might be due to the thinner cell wall structure compared to S. aureus. This finding is in agreement with our previous report [40]. The mechanism of antibacterial action of Ag3PO4 NPs can be explained similarly to the degradation of MB dye. The Ag3PO4 NPs can adhere to the cell wall and may lead to the destruction of the membrane [53]. As Ag3PO4 is a semiconductor material, it generates electron–hole pairs under light irradiation. The generation of active species (−OH) from the electron–hole pairs may affect the cell membrane, cellular protein, and DNA, leading to the death of bacteria [17,54,55]. In addition, silver ions released from the Ag3PO4 may interact with the thiol groups of numerous essential enzymes and inactive them, destroying bacteria [56]. The results demonstrate the excellent antibacterial performance of the as-prepared Ag3PO4–FA/PU NFs membrane.
Figure 6.
Antibacterial performance of various samples against E. coli (A) and S. aureus (B).
4. Conclusions
In summary, we prepared an Ag3PO4–FA/PU NFs membrane that can act as a powerful photocatalyst to eliminate organic pollutants and pathogens in water. Herein, fly ash, a waste material, was employed as an adsorbent, Ag3PO4 NPs were used as effective semiconductor photocatalytic materials, and the electrospun PU NFs membrane was taken as a substrate to deposit FA and Ag3PO4 NPs. The incorporation of FA and Ag3PO4 exhibited excellent performance for the photocatalytic degradation of MB dye and disinfection of E. coli and S. aureus bacteria. The obtained results from this study suggested that the prepared photocatalyst can be considered a prominent candidate for environmental remediation.
Author Contributions
Conceptualization B.P.; methodology, B.P. and E.M.; software, B.P. and A.A.K.; validation, B.P. and M.P.; formal analysis, B.P. and A.A.K.; investigation, B.P. and M.P.; resources, M.P.; data curation, B.P. and A.A.K.; writing—original draft preparation, B.P.; writing—review and editing, B.P.; visualization, B.P.; supervision, M.P.; project administration, M.P.; funding acquisition, M.P. All authors have read and agreed to the published version of the manuscript.
Funding
The financial support was provided by Specialized Crop Technology Development Project through Regional agricultural research base and strategic crop development project funded by Rural Development Administration; Grant number: RS-2024-00439024. This work was also supported by the Carbon-Agricultural Livestock Industry Project of Jeollabuk-do, South Korea.
Data Availability Statement
Data are contained within the article.
Conflicts of Interest
The authors declare no conflicts of interest.
References
- Nguyen, H.-H.T.; Nguyen, H.T.; Ahmed, S.F.; Rajamohan, N.; Yusuf, M.; Sharma, A.; Arunkumar, P.; Deepanraj, B.; Tran, H.-T.; Al-Gheethi, A.; et al. Emerging waste-to-wealth applications of fly ash for environmental remediation: A review. Environ. Res. 2023, 227, 115800. [Google Scholar] [CrossRef] [PubMed]
- Zhang, Y.; Liu, L. Fly ash-based geopolymer as a novel photocatalyst for degradation of dye from wastewater. Particuology 2013, 11, 353–358. [Google Scholar] [CrossRef]
- Pant, B.; Ojha, G.P.; Kim, H.-Y.; Park, M.; Park, S.-J. Fly-ash-incorporated electrospun zinc oxide nanofibers: Potential material for environmental remediation. Environ. Pollut. 2019, 245, 163–172. [Google Scholar] [CrossRef] [PubMed]
- Chen, Y.; Fan, Y.; Huang, Y.; Liao, X.; Xu, W.; Zhang, T. A comprehensive review of toxicity of coal fly ash and its leachate in the ecosystem. Ecotoxicol. Environ. Saf. 2024, 269, 115905. [Google Scholar] [CrossRef]
- Bhatt, A.; Priyadarshini, S.; Acharath Mohanakrishnan, A.; Abri, A.; Sattler, M.; Techapaphawit, S. Physical, chemical, and geotechnical properties of coal fly ash: A global review. Case Stud. Constr. Mater. 2019, 11, e00263. [Google Scholar] [CrossRef]
- Wang, C.-Q.; Liu, K.; Huang, D.-M.; Chen, Q.; Tu, M.-J.; Wu, K.; Shui, Z.-H. Utilization of fly ash as building material admixture: Basic properties and heavy metal leaching. Case Stud. Constr. Mater. 2022, 17, e01422. [Google Scholar] [CrossRef]
- Saud, P.S.; Pant, B.; Park, M.; Chae, S.-H.; Park, S.-J.; Ei-Newehy, M.; Al-Deyab, S.S.; Kim, H.-Y. Preparation and photocatalytic activity of fly ash incorporated TiO2 nanofibers for effective removal of organic pollutants. Ceram. Int. 2015, 41, 1771–1777. [Google Scholar] [CrossRef]
- Gadore, V.; Ahmaruzzaman, M. Fly ash–based nanocomposites: A potential material for effective photocatalytic degradation/elimination of emerging organic pollutants from aqueous stream. Environ. Sci. Pollut. Res. 2021, 28, 46910–46933. [Google Scholar] [CrossRef]
- Aigbe, U.O.; Ukhurebor, K.E.; Onyancha, R.B.; Osibote, O.A.; Darmokoesoemo, H.; Kusuma, H.S. Fly ash-based adsorbent for adsorption of heavy metals and dyes from aqueous solution: A review. J. Mater. Res. Technol. 2021, 14, 2751–2774. [Google Scholar] [CrossRef]
- Alinnor, I.J. Adsorption of heavy metal ions from aqueous solution by fly ash. Fuel 2007, 86, 853–857. [Google Scholar] [CrossRef]
- Park, M.; Kuk, Y.-S.; Kwon, O.H.; Acharya, J.; Ojha, G.P.; Ko, J.-K.; Kong, H.-S.; Pant, B. Fly Ash-Incorporated Polystyrene Nanofiber Membrane as a Fire-Retardant Material: Valorization of Discarded Materials. Nanomaterials 2022, 12, 3811. [Google Scholar] [CrossRef] [PubMed]
- Wang, S.; Ma, Q.; Zhu, Z.H. Characteristics of coal fly ash and adsorption application. Fuel 2008, 87, 3469–3473. [Google Scholar] [CrossRef]
- Eteba, A.; Bassyouni, M.; Saleh, M. Utilization of chemically modified coal fly ash as cost-effective adsorbent for removal of hazardous organic wastes. Int. J. Environ. Sci. Technol. 2023, 20, 7589–7602. [Google Scholar] [CrossRef]
- Ökte, A.N.; Karamanis, D.; Tuncel, D. Dual functionality of TiO2-flyash nanocomposites: Water vapor adsorption and photocatalysis. Catal. Today 2014, 230, 205–213. [Google Scholar] [CrossRef]
- Rafaie, H.A.; Ramli, N.I.T.; Khusaimi, Z.; Mohd Sarjidan, M.A.; Dulyaseree, P.; Hir, Z.A.M. Ag2CO3-Based Photocatalyst with Enhanced Photocatalytic Activity for Endocrine-Disrupting Chemicals Degradation: A Review. Catalysts 2023, 13, 540. [Google Scholar] [CrossRef]
- Pant, B.; Park, M.; Park, S.-J. Hydrothermal synthesis of Ag2CO3-TiO2 loaded reduced graphene oxide nanocomposites with highly efficient photocatalytic activity. Chem. Eng. Commun. 2020, 207, 688–695. [Google Scholar] [CrossRef]
- Pant, B.; Prasad Ojha, G.; Acharya, J.; Park, M. Ag3PO4-TiO2-Carbon nanofiber Composite: An efficient Visible-light photocatalyst obtained from electrospinning and hydrothermal methods. Sep. Purif. Technol. 2021, 276, 119400. [Google Scholar] [CrossRef]
- Qian, Y.; Shi, J.; Yang, X.; Yuan, Y.; Liu, L.; Zhou, G.; Yi, J.; Wang, X.; Wang, S. Integration of biochar into Ag3PO4/α-Fe2O3 heterojunction for enhanced reactive oxygen species generation towards organic pollutants removal. Environ. Pollut. 2022, 303, 119131. [Google Scholar] [CrossRef]
- Tavakoli, F.; Badiei, A.; Mohammadi Ziarani, G.; Tarighi, S. Photocatalytic Application of TiO2–AgI Hybrid for Degradation of Organic Pollutants in Water. Int. J. Environ. Res. 2017, 11, 217–224. [Google Scholar] [CrossRef]
- Su, J.; Fan, Y.; Yan, Y.; Liu, T.; Li, H.; Li, Z.; Song, F. A one-pot synthesis of AgBr/Ag3PO4 composite photocatalysts. RSC Adv. 2021, 11, 9865–9873. [Google Scholar] [CrossRef]
- Saud Prem, S.; Ghouri Zafar, K.; Pant, B.; An, T.; Lee Joong, H.; Park, M.; Kim, H.-Y. Photocatalytic degradation and antibacterial investigation of nano synthesized Ag3VO4 particles @PAN nanofibers. Carbon Lett. 2016, 18, 30–36. [Google Scholar] [CrossRef]
- Thiyagarajan, S.; Singh, S.; Bahadur, D. Reusable sunlight activated photocatalyst Ag3PO4 and its significant antibacterial activity. Mater. Chem. Phys. 2016, 173, 385–394. [Google Scholar] [CrossRef]
- Al Kausor, M.; Gupta, S.S.; Chakrabortty, D. Ag3PO4-based nanocomposites and their applications in photodegradation of toxic organic dye contaminated wastewater: Review on material design to performance enhancement. J. Saudi Chem. Soc. 2020, 24, 20–41. [Google Scholar] [CrossRef]
- Luo, L.; Li, Y.; Hou, J.; Yang, Y. Visible photocatalysis and photostability of Ag3PO4 photocatalyst. Appl. Surf. Sci. 2014, 319, 332–338. [Google Scholar] [CrossRef]
- Krungchanuchat, S.; Ekthammathat, N.; Phuruangrat, A.; Thongtem, S.; Thongtem, T. High UV-visible photocatalytic activity of Ag3PO4 dodecahedral particles synthesized by a simple hydrothermal method. Mater. Lett. 2017, 201, 58–61. [Google Scholar] [CrossRef]
- Saud, P.S.; Pant, B.; Ojha, G.P.; Kim, D.-U.; Kuk, Y.-S.; Park, S.-J.; Park, M.; Kim, H.-Y. One-pot synthesis of Ag3PO4/MoS2 nanocomposite with highly efficient photocatalytic activity. J. Environ. Chem. Eng. 2017, 5, 5521–5527. [Google Scholar] [CrossRef]
- Ma, P.; Yu, Y.; Xie, J.; Fu, Z. Ag3PO4/CuO composites utilizing the synergistic effect of photocatalysis and Fenton-like catalysis to dispose organic pollutants. Adv. Powder Technol. 2017, 28, 2797–2804. [Google Scholar] [CrossRef]
- Lu, J.; Wang, Y.; Liu, F.; Zhang, L.; Chai, S. Fabrication of a direct Z-scheme type WO3/Ag3PO4 composite photocatalyst with enhanced visible-light photocatalytic performances. Appl. Surf. Sci. 2017, 393, 180–190. [Google Scholar] [CrossRef]
- Liu, L.; Qi, Y.; Lu, J.; Lin, S.; An, W.; Liang, Y.; Cui, W. A stable Ag3PO4@g-C3N4 hybrid core@shell composite with enhanced visible light photocatalytic degradation. Appl. Catal. B Environ. 2016, 183, 133–141. [Google Scholar] [CrossRef]
- Liu, W.; Wang, M.; Xu, C.; Chen, S.; Fu, X. Ag3PO4/ZnO: An efficient visible-light-sensitized composite with its application in photocatalytic degradation of Rhodamine B. Mater. Res. Bull. 2013, 48, 106–113. [Google Scholar] [CrossRef]
- Pant, B.; Park, M.; Park, S.-J. Drug Delivery Applications of Core-Sheath Nanofibers Prepared by Coaxial Electrospinning: A Review. Pharmaceutics 2019, 11, 305. [Google Scholar] [CrossRef] [PubMed]
- Govind Kumar, S.; Nirmala Rachel, J. Electrospinning: The Technique and Applications. In Recent Developments in Nanofibers Research; Maaz, K., Samson Jerold Samuel, C., Eds.; IntechOpen: Rijeka, Croatia, 2022; Chapter 1. [Google Scholar]
- Pant, B.; Park, M.; Park, S.-J. MoS2/CdS/TiO2 ternary composite incorporated into carbon nanofibers for the removal of organic pollutants from water. Inorg. Chem. Commun. 2019, 102, 113–119. [Google Scholar] [CrossRef]
- Pathak, D.; Sharma, A.; Sharma, D.P.; Kumar, V. A review on electrospun nanofibers for photocatalysis: Upcoming technology for energy and environmental remediation applications. Appl. Surf. Sci. Adv. 2023, 18, 100471. [Google Scholar] [CrossRef]
- Samadi, M.; Moshfegh, A.Z. Recent Developments of Electrospinning-Based Photocatalysts in Degradation of Organic Pollutants: Principles and Strategies. ACS Omega 2022, 7, 45867–45881. [Google Scholar] [CrossRef]
- Yousef, A.; Barakat, N.A.M.; Al-Deyab, S.S.; Nirmala, R.; Pant, B.; Kim, H.Y. Encapsulation of CdO/ZnO NPs in PU electrospun nanofibers as novel strategy for effective immobilization of the photocatalysts. Colloids Surf. A Physicochem. Eng. Asp. 2012, 401, 8–16. [Google Scholar] [CrossRef]
- Yu, H.; Jiao, Z.; Hu, H.; Lu, G.; Ye, J.; Bi, Y. Fabrication of Ag3PO4–PAN composite nanofibers for photocatalytic applications. CrystEngComm 2013, 15, 4802–4805. [Google Scholar] [CrossRef]
- Habib, Z.; Lee, C.-G.; Li, Q.; Khan, S.J.; Ahmad, N.M.; Jamal, Y.; Huang, X.; Javed, H. Bi-Polymer Electrospun Nanofibers Embedding Ag3PO4/P25 Composite for Efficient Photocatalytic Degradation and Anti-Microbial Activity. Catalysts 2020, 10, 784. [Google Scholar] [CrossRef]
- Pant, B.; Park, M.; Park, S.-J. One-Step Synthesis of Silver Nanoparticles Embedded Polyurethane Nano-Fiber/Net Structured Membrane as an Effective Antibacterial Medium. Polymers 2019, 11, 1185. [Google Scholar] [CrossRef]
- Pant, B.; Munkhtur, E.; Prasad Ojha, G.; Acharya, J.; Hong, S.-T.; Park, M. Hydrothermally synthesized ZnO/WS2 composite with impressive photocatalytic, antibacterial, and electrochemical performances. Inorg. Chem. Commun. 2024, 166, 112630. [Google Scholar] [CrossRef]
- Li, J.; Ji, X.; Li, X.; Hu, X.; Sun, Y.; Ma, J.; Qiao, G. Preparation and photocatalytic degradation performance of Ag3PO4 with a two-step approach. Appl. Surf. Sci. 2016, 372, 30–35. [Google Scholar] [CrossRef]
- Pant, H.R.; Kim, H.J.; Joshi, M.K.; Pant, B.; Park, C.H.; Kim, J.I.; Hui, K.S.; Kim, C.S. One-step fabrication of multifunctional composite polyurethane spider-web-like nanofibrous membrane for water purification. J. Hazard. Mater. 2014, 264, 25–33. [Google Scholar] [CrossRef] [PubMed]
- Gu, X.; Li, N.; Luo, J.; Xia, X.; Gu, H.; Xiong, J. Electrospun polyurethane microporous membranes for waterproof and breathable application: The effects of solvent properties on membrane performance. Polym. Bull. 2018, 75, 3539–3553. [Google Scholar] [CrossRef]
- Jirofti, N.; Mohebbi-Kalhori, D.; Samimi, A.; Hadjizadeh, A.; Kazemzadeh, G.H. Fabrication and characterization of a novel compliant small-diameter PET/PU/PCL triad-hybrid vascular graft. Biomed. Mater. 2020, 15, 055004. [Google Scholar] [CrossRef]
- Joshi, M.K.; Pant, H.R.; Liao, N.; Kim, J.H.; Kim, H.J.; Park, C.H.; Kim, C.S. In-situ deposition of silver−iron oxide nanoparticles on the surface of fly ash for water purification. J. Colloid Interface Sci. 2015, 453, 159–168. [Google Scholar] [CrossRef]
- Tong, Z.W.; Yang, D.; Sun, Y.Y.; Tian, Y.; Jiang, Z.Y. In situ fabrication of Ag3PO4/TiO2 nanotube heterojunctions with enhanced visible-light photocatalytic activity. Phys. Chem. Chem. Phys. 2015, 17, 12199–12206. [Google Scholar] [CrossRef]
- Dinh, N.T.; Vo, L.N.H.; Tran, N.T.T.; Phan, T.D.; Nguyen, D.B. Enhancing the removal efficiency of methylene blue in water by fly ash via a modified adsorbent with alkaline thermal hydrolysis treatment. RSC Adv. 2021, 11, 20292–20302. [Google Scholar] [CrossRef]
- Yu, C.; Chen, X.; Li, N.; Zhang, Y.; Li, S.; Chen, J.; Yao, L.; Lin, K.; Lai, Y.; Deng, X. Ag3PO4-based photocatalysts and their application in organic-polluted wastewater treatment. Environ. Sci. Pollut. Res. 2022, 29, 18423–18439. [Google Scholar] [CrossRef]
- Pant, B.; Jung, S.; Park, M. Ion-exchange formation of Ag2CO3-Ag3PO4 binary nanostructure on electrospun polyurethane nanofibers for enhanced photocatalytic degradation and antibacterial activities. Mater. Today Commun. 2024, 41, 110913. [Google Scholar] [CrossRef]
- Xiong, S.; Liu, M.; Yan, J.; Zhao, Z.; Wang, H.; Yin, X.; Wang, L.; Chen, S. Immobilization of Ag3PO4 nanoparticles on chitosan fiber for photocatalytic degradation of methyl orange. Cellulose 2018, 25, 5007–5015. [Google Scholar] [CrossRef]
- Tao, R.; Yang, S.; Shao, C.; Li, X.; Li, X.; Liu, S.; Zhang, J.; Liu, Y. Reusable and Flexible g-C3N4/Ag3PO4/Polyacrylonitrile Heterojunction Nanofibers for Photocatalytic Dye Degradation and Oxygen Evolution. ACS Appl. Nano Mater. 2019, 2, 3081–3090. [Google Scholar] [CrossRef]
- Liu, J.; Liang, H.; Xing, Z.; Wang, X.; Bai, J. Synthesis of Bi-BiPO4-Ag3PO4/PAN composite nanomaterial photocatalyst with the degradation performance for rhodamine B. Mater. Sci. Semicond. Process. 2025, 185, 108918. [Google Scholar] [CrossRef]
- Dânoun, K.; Tabit, R.; Laghzizil, A.; Zahouily, M. A novel approach for the synthesis of nanostructured Ag3PO4 from phosphate rock: High catalytic and antibacterial activities. BMC Chem. 2021, 15, 42. [Google Scholar] [CrossRef] [PubMed]
- Xu, J.-W.; Gao, Z.-D.; Han, K.; Liu, Y.; Song, Y.-Y. Synthesis of Magnetically Separable Ag3PO4/TiO2/Fe3O4 Heterostructure with Enhanced Photocatalytic Performance under Visible Light for Photoinactivation of Bacteria. ACS Appl. Mater. Interfaces 2014, 6, 15122–15131. [Google Scholar] [CrossRef]
- Lyu, Y.-h.; Wei, F.; Zhang, T.; Luo, L.; Pan, Y.; Yang, X.; Yu, H.; Zhou, S. Different antibacterial effect of Ag3PO4/TiO2 heterojunctions and the TiO2 polymorphs. J. Alloys Compd. 2021, 876, 160016. [Google Scholar] [CrossRef]
- Agbe, H.; Sarkar, D.K.; Chen, X.G. Electrochemically synthesized silver phosphate coating on anodized aluminum with superior antibacterial properties. Surf. Coat. Technol. 2021, 428, 127892. [Google Scholar] [CrossRef]
Disclaimer/Publisher’s Note: The statements, opinions and data contained in all publications are solely those of the individual author(s) and contributor(s) and not of MDPI and/or the editor(s). MDPI and/or the editor(s) disclaim responsibility for any injury to people or property resulting from any ideas, methods, instructions or products referred to in the content. |
© 2025 by the authors. Licensee MDPI, Basel, Switzerland. This article is an open access article distributed under the terms and conditions of the Creative Commons Attribution (CC BY) license (https://creativecommons.org/licenses/by/4.0/).